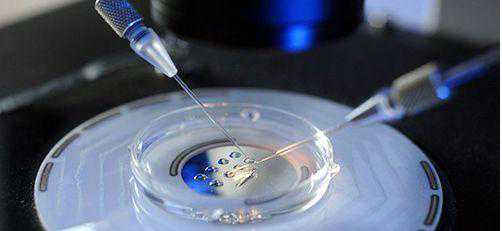
香港验血验性别多少钱_(谈谈我的经验),香港明爱诊所能验血吗

香港验血验性别多少钱_(谈谈我的经验),香港明爱诊所能验血吗
联络微信在线进行具体的咨询!7*24小时在线为您供给免费咨询服务!
联络微信在线进行具体的咨询!7*24小时在线为您供给免费咨询服务!
标签:
相关问题
- 2026-02-09奇思妙想喜羊羊全集目录
- 2026-02-062020日本私人影视《喜羊羊与灰太狼之奇思妙想喜羊羊》 高清完整版免费在线观
- 2026-01-31这部动漫动漫
- 2026-01-29古灵精探第01集在线免费观看
- 2026-01-26广电总局公布2008年度全国少儿节目评审结果(3)
- 2026-01-20【魔幻动漫排行榜】
- 2026-01-19《奇幻☆怪盗》全集免费在线观看
- 2026-01-08奇妙小镇的剧情简介
- 2026-01-07奇妙小镇的电影剧情
- 2026-01-03奇妙小镇的每集名称
-
11动漫公司
11动漫公司提供最快最全的动漫、手办周边、游戏及声优情报。快来与千万动漫迷一起吐槽最新的二次元动态吧。
- 最新文章
- 热门文章
- 热评文章
- 随机tag
-